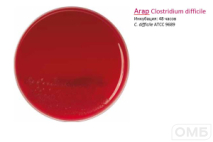
Clostridium difficile agar -  Агар для селективного выделения Clostrium difficile

Питательные среды

Нужен совет, как выбрать оборудование или использовать его?
Просто опишите ваши ожидания — эксперты Компании ОМБ подберут несколько подходящих товаров и подробно расскажут об их возможностях.
Связаться с нами можно по телефону
+7 495 925-81-50 или заполнив форму.

Внимание!
Размещенная на сайте www.omb.ru информация (в том числе рекламного характера), а также графические образы и изображения медицинских изделий представлены исключительно для сотрудников медицинских организаций/медицинских работников - пользователей медицинских изделий и поставщиков медицинских изделий.
Нажимая на кнопку «Продолжить» и оставаясь на указанном сайте, вы подтверждаете, что являетесь медицинским работником, либо поставщиком медицинских изделий и принимаете на себя ответственность за несоблюдение указанного ограничения.